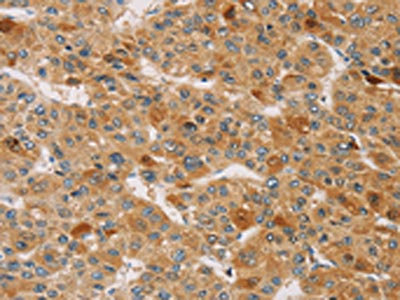

TRIM40 Antibody
-
中文名稱:TRIM40兔多克隆抗體
-
貨號:CSB-PA263066
-
規(guī)格:¥1100
-
圖片:
-
The image on the left is immunohistochemistry of paraffin-embedded Human liver cancer tissue using CSB-PA263066(TRIM40 Antibody) at dilution 1/40, on the right is treated with synthetic peptide. (Original magnification: ×200)
-
The image on the left is immunohistochemistry of paraffin-embedded Human thyroid cancer tissue using CSB-PA263066(TRIM40 Antibody) at dilution 1/40, on the right is treated with synthetic peptide. (Original magnification: ×200)
-
-
其他:
產(chǎn)品詳情
-
Uniprot No.:
-
基因名:TRIM40
-
別名:TRIM40 antibody; RNF35 antibody; Tripartite motif-containing protein 40 antibody; Probable E3 NEDD8-protein ligase antibody; RING finger protein 35 antibody
-
宿主:Rabbit
-
反應(yīng)種屬:Human
-
免疫原:Synthetic peptide of Human TRIM40
-
免疫原種屬:Homo sapiens (Human)
-
標記方式:Non-conjugated
-
抗體亞型:IgG
-
純化方式:Antigen affinity purification
-
濃度:It differs from different batches. Please contact us to confirm it.
-
保存緩沖液:-20°C, pH7.4 PBS, 0.05% NaN3, 40% Glycerol
-
產(chǎn)品提供形式:Liquid
-
應(yīng)用范圍:ELISA,IHC
-
推薦稀釋比:
Application Recommended Dilution ELISA 1:1000-1:2000 IHC 1:25-1:100 -
Protocols:
-
儲存條件:Upon receipt, store at -20°C or -80°C. Avoid repeated freeze.
-
貨期:Basically, we can dispatch the products out in 1-3 working days after receiving your orders. Delivery time maybe differs from different purchasing way or location, please kindly consult your local distributors for specific delivery time.
-
用途:For Research Use Only. Not for use in diagnostic or therapeutic procedures.
相關(guān)產(chǎn)品
靶點詳情
-
功能:E3 ubiquitin-protein ligase that plays a role in the limitation of the innate immune response. Mediates inhibition of the RLR signaling pathway by ubiquitinating DDX58 and IFIH1 receptors, leading to their proteasomal degradation. Promotes also the neddylation of IKBKG/NEMO, stabilizing NFKBIA, and thereby inhibiting of NF-kappa-B nuclear translocation and activation.
-
基因功能參考文獻:
- findings suggest that TRIM40 inhibits NF-kappaB activity via neddylation of inhibitor of nuclear factor kappaB kinase subunit gamma and that TRIM40 prevents inflammation-associated carcinogenesis in the gastrointestinal tract PMID: 21474709
-
蛋白家族:TRIM/RBCC family
-
組織特異性:Highly expressed in normal gastrointestinal epithelia but that is down-regulated in gastrointestinal carcinomas and chronic inflammatory lesions of the gastrointestinal tract.
-
數(shù)據(jù)庫鏈接:
Most popular with customers
-
YWHAB Recombinant Monoclonal Antibody
Applications: ELISA, WB, IHC, IF, FC
Species Reactivity: Human, Mouse, Rat
-
Phospho-YAP1 (S127) Recombinant Monoclonal Antibody
Applications: ELISA, WB, IHC
Species Reactivity: Human
-
-
-
-
-
-